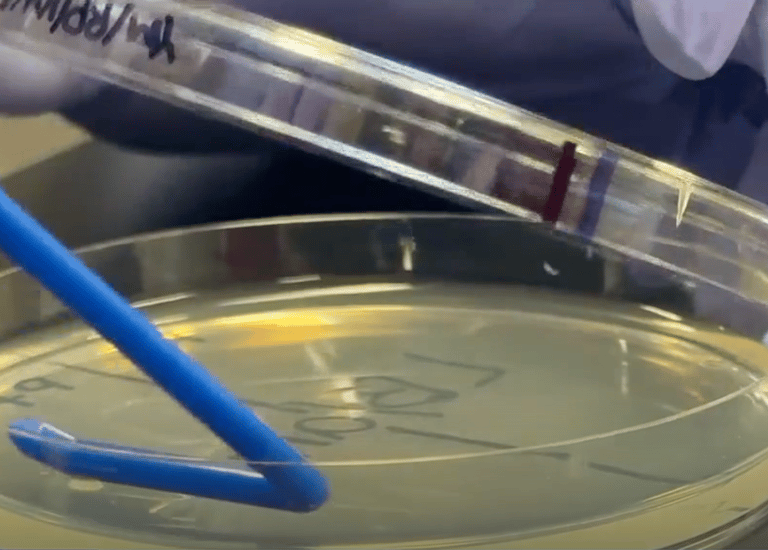
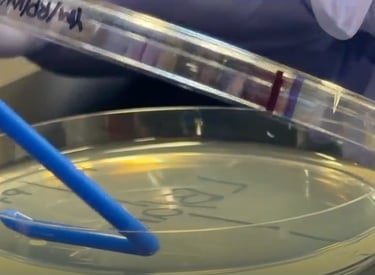

Reviving Florida's Citrus Heritage
Join us in restoring Citrus heritage of Florida
Florida once produced over 70% of America’s oranges — but today, Citrus Greening Disease (HLB) has devastated groves, wiping out more than 90% of yields and reducing production from 242 million to just 15 million boxes.
Save Citrus is uniting growers, scientists, and communities to fight back — one grove, one tree, one breakthrough at a time.
OUR MISSION
The Citrus Greening Disease is known as the most prominent disease threat to the citrus growing industry worldwide, causing significant declines in orange production across North America, South America, Asia, and Africa.
In Florida, United States, the disease has resulted in nearly a 90% loss in orange production. Until 2016, my home state Florida used to be the #1 citrus producing region in the United States, ranking among the top three orange producers globally. Over the last two decades, however, this disease has affected over 80% of the citrus trees in Florida. Over time, the orange production dropped from 242 million boxes to merely 15 million boxes. It is evident that the once thriving hallmark of citrus production-the Florida Citrus Industry-has been reduced to a shadow of its former self and farmers have been struggling to address this crisis.
With no current cure for this disease, this project aimed to accomplish 3 main goals:
Development of a Sustainable and Eco-Friendly Treatment for Citrus Greening Disease
Engage in hands-on-conservation of citrus groves and Mobilize Treatments to Farmers
Lead a two-year community-driven campaign focused on Agricultural Sustainability and Advocacy.
Ultimately, this project holds the potential to revive the Florida and global citrus industry and preserve its agricultural heritage through the revitalization of citrus groves.
WHY IT MATTERS
The Crisis We Must Address
Florida’s citrus sector once generated enough fruit to nourish the nation. Currently, its production is at all-time lows—resulting in thousands of acres of orchards being left unattended.
The Challenges:
🍊 Citrus Greening Disease – The foremost danger to international citrus, gradually damaging trees from within.
🌎 Climate Change & Water Stress – Droughts, hurricanes, and soil deterioration are hindering recovery.
👨🌾 Farm Economics – Family-operated groves can no longer thrive without collective assistance.
Save Citrus aims to shift that narrative—transforming scientific knowledge and community action into enduring sustainability.
Project
Turning Concern Into Action
Research & Innovation
Development of Sustainable Treatment
With over 3 years of research, I developed a Grower-Friendly Disease Management Kit: A Sustainable Curry Leaf Extract-Based Treatment and 3D-Engineered Treatment Delivery System for Citrus Greening Disease Management. This achieved a nearly 70% eradication efficacy of the disease and can serve as a broad-spectrum alternative to synthetic pesticides. This revolutionizes sustainable agriculture, reducing synthetic chemical inputs globally.
Hands on Conservation
Mobilization to Restore Citrus Groves
I collaborated with the U.S. Department of Agriculture and the Citrus Research and Development Foundation to mobilize my innovation to numerous farmers across Florida. Over 1,500 Citrus Trees were planted for citrus restoration. I was also able to distribute 11,465 trees through 16 tree donation events.
Advocacy and Sustainability Education
I authored the Children’s book, “Story of Oranges” selling across 3 different countries, to educate the next-generation of youth on the Florida citrus crisis and overcoming environmental pesticide pollution in agriculture. I also addressed growers and delivered online educational talks to growers of 11 different major citrus growing countries with over 1,000 individuals being reached through a variety of presentations.
Advocacy & Education
Gallery & Testimonials
Real People. Real Impact.
News & Media

Publications
The Story of Oranges: A Tale of Agriculture, Sustainability, and Hope:
Author: Tanishka Aglave
Embark on an inspiring journey through Florida’s treasured Orange Groves to uncover the challenges of one of the world’s most cherished fruits.
Florida is one of the largest producer of oranges in the U.S., contributing significantly to the global citrus industry. Oranges are not just a beloved fruit but a pillar of Florida's agriculture and economy. However, in recent years, citrus farmers in Florida and across the globe have been grappling unprecedented losses, threatening the future of this vital crop. To combat this challenge, a community of farmers, scientists, leaders, and most importantly young advocates must come together to build a stronger, more sustainable future!
PLNT016 - Sustainable Citrus Greening Disease Management
Huanglongbing (HLB), or the Citrus Greening (Candidatus Liberibacter asiaticus), is the most destructive citrus disease worldwide and persists in threatening the sustainability of the Citrus Industry in numerous regions. Currently, no pesticide is registered to cure this disease besides the antibiotic Oxytetracycline and streptomycin sulphate under the emergency label section 18 ...
PLNT024 - Sustainable Citrus Greening Disease Management
Huanglongbing (HLB) or the Citrus Greening Disease (Candidatus Liberibacter asiaticus) is the most destructive citrus disease worldwide. Currently, no pesticide is registered to cure this disease besides Oxytetracyline under Emergency Label Section 18. The curry leaf tree, Murraya koenigii, is highly attractive to the Asian citrus psyllid, Diaphorina citri, which vectors the bacterial causative agent of citrus greening disease, but it is not a carrier of disease ...
Author:Tanishka Aglave, Douglas Stuehler Jr., Frank Sances, and Michelle L. Heck
Abstract
We developed a Murraya koenigii (curry) leaf extract and evaluated its use as a citrus tree-health supportive input by trunk injection for citrus under field-relevant biotic and abiotic stress in Florida, where there is heavy pressure from the vector borne-disease, Huanglongbing (HLB), also known as citrus greening disease. In greenhouse and juvenile-tree field observations, citrus tree trunk injection with higher curry leaf extract concentrations were associated with increased canopy vigor, higher chlorophyll index and favorable leaf-appearance ratings over time. We report qPCR measurements as exploratory research metrics only and not as a pesticidal claim. These findings justify further study of curry leaf and similar plant-derived preparations to support citrus tree physiology in challenging commercial production environments.
Trunk injection of a curry leaf extract to promote citrus tree health in Huanglongbing-endemic regions
Awards
REGENERON International Science and Engineering (ISEF) Fair 1st Place Grand Award Winner ($10,000) (2024)
Regeneron ISEF Top Award Winner 2024: H. Robert Horvitz Prize for Fundamental Research (2024)
U.S. Environmental Protection Agency President’s Environmental Youth Award (PEYA) (2025)
Regeneron International Science and Engineering Fair (ISEF) 2nd Place Grand Award Winner ($2,400) (2025)
National 3rd and 2nd Prize Winner at U.S. Nationals Invention Convention at Henry Ford (2024)
National Junior Science and Humanities Symposium (JSHS) Finalist in Oral Presentation Environmental Sciences (2025)
American Chemical Society National Symposium Top 10 Winners
Media Mention
President's Environmental Youth Award
Strawberry Crest High School Student Wins ...
Hillsborough County student wins prestigious award
for work addressing citrus greening disease
SCIENTIST, AUTHOR
STRAWBERRY CREST HIGH SCHOOL STUDENT
Teenager Awarded
for Investigation of Alternative Trunk-Injection Treatment.
Young innovator, big impact
Tanishka Aglave’s fight against crop disease...
Florida Teen’s Citrus Innovation
Earns National Environmental Award
Additional Media Mentions:
Latest citrus research served with dinner | Highlands News-Sun | midfloridanewspapers.com
STRAWBERRY CREST STUDENT AWARDED SCIENCE PRIZE | Plant City Observer
H. Robert Horvitz Prize for Fundamental Research - Society for Science
Teenager awarded for investigation of alternative trunk-injection treatment for HLB | Agriculture | thedesertreview.com
Contact Us
Stay Connected to the Cause
We’d love to hear from you. Have ideas, questions, or want to collaborate? Let’s talk.
📍 Based in Florida, serving growers statewide
Contact
info@savecitrus.com
Save Citrus™ — An initiative dedicated to reviving Florida’s citrus heritage.
© 2025. All rights reserved.